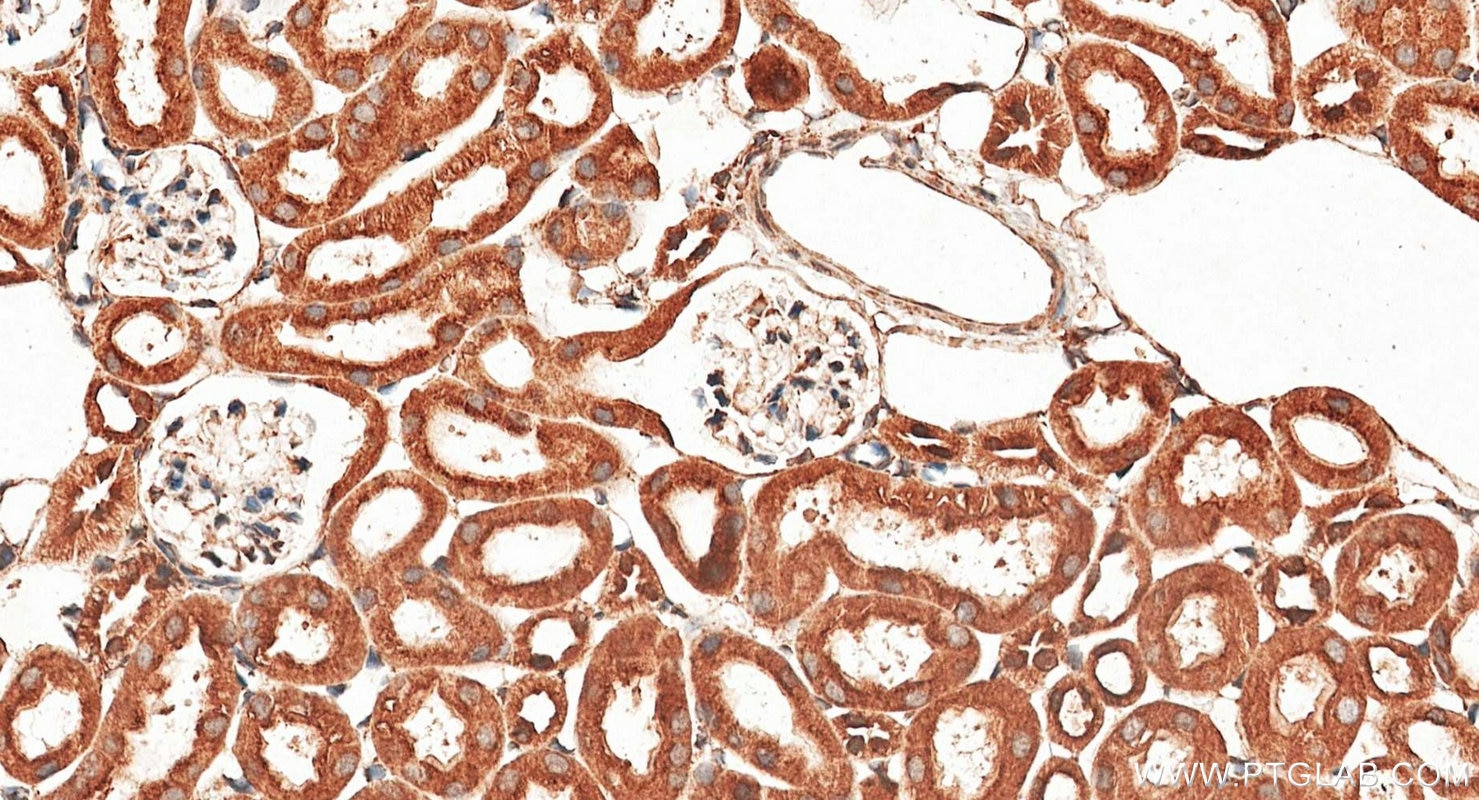
Immunohistochemistry (IHC) staining of mouse kidney tissue using calreticulin Polyclonal antibody (27298-1-AP)

Tested Applications
| Positive WB detected in | HeLa cells, mouse skeletal muscle tissue, C6 cells, NIH/3T3 cells, mouse brain tissue, rat brain tissue, SH-SY5Y cells |
| Positive IHC detected in | human thyroid tissue, human colon tissue, mouse kidney tissue Note: suggested antigen retrieval with TE buffer pH 9.0; (*) Alternatively, antigen retrieval may be performed with citrate buffer pH 6.0 |
| Positive IF-P detected in | mouse kidney tissue |
| Positive IF/ICC detected in | HepG2 cells, SKOV-3 cells, HeLa cells |
| Positive FC (Intra) detected in | HeLa cells |
Recommended dilution
| Application | Dilution |
|---|---|
| Western Blot (WB) | WB : 1:20000-1:100000 |
| Immunohistochemistry (IHC) | IHC : 1:50-1:500 |
| Immunofluorescence (IF)-P | IF-P : 1:50-1:500 |
| Immunofluorescence (IF)/ICC | IF/ICC : 1:50-1:500 |
| Flow Cytometry (FC) (INTRA) | FC (INTRA) : 0.40 ug per 10^6 cells in a 100 µl suspension |
| It is recommended that this reagent should be titrated in each testing system to obtain optimal results. | |
| Sample-dependent, Check data in validation data gallery. | |
Published Applications
| WB | See 30 publications below |
| IHC | See 6 publications below |
| IF | See 52 publications below |
Product Information
27298-1-AP targets calreticulin in WB, IHC, IF/ICC, IF-P, FC (Intra), ELISA applications and shows reactivity with human, mouse, rat samples.
| Tested Reactivity | human, mouse, rat |
| Cited Reactivity | human, mouse, rat, monkey |
| Host / Isotype | Rabbit / IgG |
| Class | Polyclonal |
| Type | Antibody |
| Immunogen |
CatNo: Ag26064 Product name: Recombinant human calreticulin protein Source: e coli.-derived, PGEX-4T Tag: GST Domain: 248-417 aa of BC002500 Sequence: KKPEDWDEEMDGEWEPPVIQNPEYKGEWKPRQIDNPDYKGTWIHPEIDNPEYSPDPSIYAYDNFGVLGLDLWQVKSGTIFDNFLITNDEAYAEEFGNETWGVTKAAEKQMKDKQDEEQRLKEEEEDKKRKEEEEAEDKEDDEDKDEDEEDEEDKEEDEEEDVPGQAKDEL Predict reactive species |
| Full Name | calreticulin |
| Calculated Molecular Weight | 60 kDa |
| Observed Molecular Weight | 55 kDa |
| GenBank Accession Number | BC002500 |
| Gene Symbol | Calreticulin |
| Gene ID (NCBI) | 811 |
| RRID | AB_2880835 |
| Conjugate | Unconjugated |
| Form | Liquid |
| Purification Method | Antigen affinity purification |
| UNIPROT ID | P27797 |
| Storage Buffer | PBS with 0.02% sodium azide and 50% glycerol, pH 7.3. |
| Storage Conditions | Store at -20°C. Stable for one year after shipment. Aliquoting is unnecessary for -20oC storage. 20ul sizes contain 0.1% BSA. |
Background Information
CALR,also named as grp60, ERp60, HACBP, CRP55, CRTC and Calregulin, belongs to the calreticulin family. It is a molecular calcium-binding chaperone promoting folding, oligomeric assembly and quality control in the ER via the calreticulin/calnexin cycle. CALR is a ER marker. It interacts transiently with almost all of the monoglucosylated glycoproteins that are synthesized in the ER. CALR interacts with the DNA-binding domain of NR3C1 and mediates its nuclear export. The MW of CALR migrates aberrantly at 60 kD by SDS-PAGE. Some study provided that it's a new possibility for CRT-mediated tumor immune prevention and treatment.
Protocols
| Product Specific Protocols | |
|---|---|
| FC protocol for calreticulin antibody 27298-1-AP | Download protocol |
| IF protocol for calreticulin antibody 27298-1-AP | Download protocol |
| IHC protocol for calreticulin antibody 27298-1-AP | Download protocol |
| WB protocol for calreticulin antibody 27298-1-AP | Download protocol |
| Standard Protocols | |
|---|---|
| Click here to view our Standard Protocols |
Publications
| Species | Application | Title |
|---|---|---|
Cell Metab Transient Receptor Potential V Channels Are Essential for Glucose Sensing by Aldolase and AMPK. | ||
Nat Commun In situ generation of micrometer-sized tumor cell-derived vesicles as autologous cancer vaccines for boosting systemic immune responses | ||
Nat Commun Engineered macrophages as near-infrared light activated drug vectors for chemo-photodynamic therapy of primary and bone metastatic breast cancer. | ||
EMBO J STING directly recruits WIPI2 for autophagosome formation during STING-induced autophagy | ||
J Control Release Positron emission tomography guided synergistic treatment of melanoma using multifunctional zirconium-hematoporphyrin nanosonosensitizers | ||
ACS Appl Mater Interfaces A Versatile Nanoplatform for Broad-Spectrum Immunotherapy by Reversing the Tumor Microenvironment |